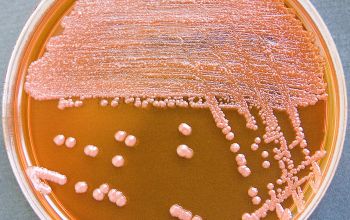
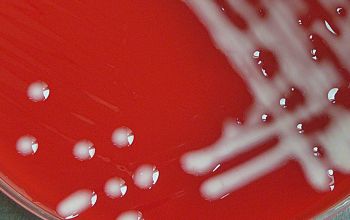

Multidrug-resistant A.baumannii has spread to civilian hospitals in part due to the transport of infected soldiers through multiple medical facilities.
Author: The U.S. Army
https://commons.wikimedia.org/wiki/File:Flickr_-_The_U.S._Army_-_Soldiers_receive_treatment_for_IED_injuries.jpg
Acinetobacter baumannii
-
General information
The name Acinetobacter (from the Greek akineto, "nonmotile") reflects the fact that these bacteria do not have flagella and consequently, lack swimming motility.
A. baumannii is part of the ACB complex (A. calcoaceticus and A. baumannii).
Taxonomy
Family: Moraxellaceae
Natural habitat
Acinetobacter species are widely distributed in nature and have been found in soil, sewage, water and in the hospital environment.
They are able to survive on moist and dry surfaces, and also be present in foodstuff and on the healthy human skin.
Clinical significance
A. baumannii ventilator-associated pneumonia and bloodstream infections have been documented to be associated with a high degree of mortality and morbidity.
Particular manifestations of A. baumannii are its implication in infections in soldiers that have been severly wounded in war and in victims of natural disasters.
Although severe infections with A. baumannii have been documented, Infections like, respiratory, urinary tract, wound infections, abscesses and meningitis in debilitated humans,
colonization is much more frequent than infection, and differentiation between these conditions can be difficult.
Still, although they are uncommon, community-acquired pneumonia with A. baumannii occur.
The ability of this microorganism to acquire antimicrobial multiresistance and his high capacity for survival on most environmental surfaces has led to an increase concern regarding hospital acquired infections.
A possible mechanism contributing to survival of A. baumannii is its ability to form a biofilm-like structure at the air/liquid interface, known as a pellicle.
-
Gram stain
Gram negative, short, almost round, rod-shaped rods,
Individual cells are 0.9-1.5 x 1.5-2.5 µm,
located often in pairs or chains of variable length.
They are sometimes difficult to decolorize
-
Culture characteristics
-
Obligate aerobic / NF (non-lactose fermenter)
BA: after 24h, colonies are 1-2 mm in diameter, colorless to beige, domed and smooth to mucoid, non-hemolytic, center growth thicker.
The colonies are slightly smaller than the Enterobacteriaceae
Colonies of encapsulated cells are generally non-pigmented and mucoid.
McConkey: colonies are pale, and can become pink.
BBAØ: no growth
-
-
Characteristics
- Gram-negative
- bacilli
- coccoid-bacilli
- growth obligate-aerobic
- catalase-positive
- oxidase-negative
- twitching motility
- vancomycin-resistant
- colistine-susceptible
- citrate-positive
- motility: cells exhibit twitching motility due to prescence of polar fimbriae.
- capsules: many strains are encapsulated and can be seen in India ink wet mounts
- pellicle: a biofilm-like structure at the air/liquid interface
-
References
James Versalovic et al.(2011) Manual of Clinical Microbiology 10th Edition
Karen C. Carrol et al (2019) Manual of Clinical Microbiology, 12th Edition